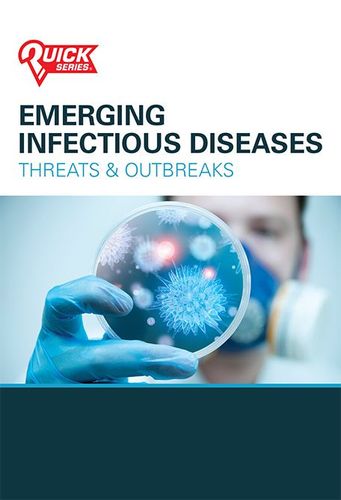

Emergency Preparedness & Management Pocket Guides and Outreach Products
Equipping people with the tools necessary to prepare for and respond to any crisis.
From natural disasters to active threats, provide citizens with the knowledge and actionable plans they need to keep themselves and their loved ones safe. Help them understand how to prepare, respond, and act during weather emergencies, active shooter events, unexpected explosions, and public health emergencies.
Try Before You Buy - Quality Guaranteed.
Get your free samples today! Contact us
New & Trending
-
 National Interoperability Field Operations Guide (NIFOG) The National Interoperability Field Operations Guide (NIFOG) is a technical...
National Interoperability Field Operations Guide (NIFOG) The National Interoperability Field Operations Guide (NIFOG) is a technical... -
 Incident Command System (ICS) Be prepared! This guide describes the Incident Command System (ICS),...
Incident Command System (ICS) Be prepared! This guide describes the Incident Command System (ICS),... -
 Active Shooter Response Active shooting situations happen without warning - that's why it's...
Active Shooter Response Active shooting situations happen without warning - that's why it's... -
 CERT Field Operations Guide The Field Operations Guide provides trained community emergency responders with...
CERT Field Operations Guide The Field Operations Guide provides trained community emergency responders with... -
 CERT Companion Guide for Advanced Operations All CERT volunteers need basic skills to protect themselves and...
CERT Companion Guide for Advanced Operations All CERT volunteers need basic skills to protect themselves and...